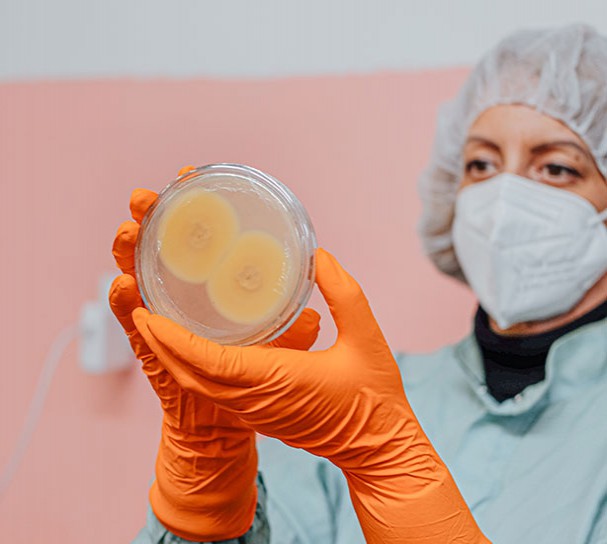

O podjetju MycoMedica d.o.o.
MycoMedica d.o.o. je visokotehnološko podjetje, v katerem na podlagi dolgoletnih raziskav razvijamo nove tehnike gojenja medicinskih in jedilnih gliv ter prehranskih dopolnil iz njih. Nad proizvodnjo imamo popoln nadzor, zato so naši produkti izdelani na okolju prijazen način v čistem gorskem okolju, zanje pa uporabljamo 100% ekološke surovine, ki jih pridelamo sami ali pridobimo izključno od preverjenih dobaviteljev iz Evropske Unije.

Lokalna ekonomija in domače znanje
Nenehno vlagamo v razvoj novih tehnik gojenja ter v dodatne izboljšave obstoječih izdelkov in tehnologij. Raziskave izvajamo znotraj lastnega razvojnega tima, kot tudi v sodelovanju z najrazličnejšimi domačimi in tujimi raziskovalnimi inštitucijami.

Brez odpadkov in kemikalij
Zavedamo se, da imajo proizvodni procesi vpliv na okolje, zato sta poraba in proizvodnja v podjetju organizirani trajnostno. Ne uporabljamo plastike za enkratno uporabo, prostore ogrevamo z obnovljivo lesno biomaso, vse substrate gob pa po uporabi kompostiramo ter uporabimo za gojenje vrtnin. Pri tem ne uporabljamo kemičnih pripravkov.
Spremljamo trende in odkrivamo priložnosti za izboljšave
Naše znanje in izkušnje nadgrajujemo s stalnim razvojem in vlaganjem v napredek. Delo razvojne skupine je usmerjeno v razvoj novih tehnik gojenja gob in v izboljšave obstoječih izdelkov in tehnologij. Pri tem sodelujemo z najrazličnejšimi domačimi in tujimi raziskovalnimi inštitucijami.


Ekološka pridelava brez kemikalij
Nad celotno proizvodnjo imamo popoln nadzor, od začetne kulture glive, sestave substratov, na katerih rastejo gobe, načinov končne predelave gob v prehranska dopolnila, kot tudi testiranj le-teh. Ker je kakovost konvencionalnih surovin iz dneva v dan bolj vprašljiva zaradi uporabe najrazličnejših pesticidov v kmetijstvu, pri proizvodnji uporabljamo izključno 100% ekološke surovine iz Evropske Unije.
Veleprodaja izdelkov in surovin
Proizvode naše blagovne znamke GOBA® lahko kupite po vsej Sloveniji, prehranska dopolnila v razsutem stanju dobavljamo številnim farmacevtskim podjetjem doma in v tujini za uporabo v njihovih izdelkih, za nekatera podjetja pa po naročilu izdelujemo proizvode za njihove lastne blagovne znamke.

Izdelki iz medicinskih gliv lastne proizvodnje
GOBA® je lastna blagovna znamka podjetja MycoMedica d.o.o. V ponudbi imamo številne izdelke iz medicinskih gliv z blagodejnimi vplivi na delovanje organizma, ki jih tržimo doma in v tujini.

Kakovost izdelkov in surovin
Redne kontrole in certificiranje pomenijo, da je naše delo kakovostno. Številna preverjanja zagotavljajo skladnost z zakonskimi zahtevami, izvajamo pa tudi prostovoljne kontrole kakovosti s strani lastnega laboratorija, javnih certificiranih laboratorijev za kontrolo kakovosti, certificiranih laboratorijev iz tujine in domačih ter tujih raziskovalnih inštitucij.
 Raziskave in projekti
Raziskave in projekti
Naložbe v lastne raziskovalne in razvojne dejavnosti ter inovacije so temelj za dolgoročni razvoj in rast podjetja. Da lahko zagotavljamo zadovoljstvo naših kupcev in jim nudimo visokokovostne izdelke, se vseskozi osredotočamo na razvoj novih tehnologij in rešitev.

Svetovanje
Svetovanje
Ogromno časa posvečamo razumevanju zdravilnih gliv, širjenju informacij o njih ter na strokoven način pomagamo našim kupcem. Stopite v stik z nami, z veseljem vam bomo svetovali in pomagali pri izbiri pravega izdelka za vas.


Objavljena prva klinična študija na našem izdelku GOBA Hericium erinaceus heteropolisaharidih. https://www.slovenskenovice.si/novice/slovenija/gorenjski-baltazar-s-cudezno-gobo-nad-demenco/

Dokazujemo da naš izdelek GOBA Galimmun učinkovito veže nase težke kovine in potencialno pomaga razstrupljati organizem. Delo poteka pod vodstvom doc.dr. Gregorja Marolta

Projekt z akronimom OEDFS predstavlja projekt interdisciplinarnega povezovanja in sodelovanja uporabo, konsolidacijo in uvedbo tehnologije digitalnega dvojčka v sektor predelave medicinskih gliv za prehranska dopolnila, z uvedbo novega sistema senzorike in avtomatizacije in digitalizacije procesov ekstrakcije in sušenja v podjetju MycoMedica d.o.o..

Kot predstavniki Slovenije Konferenci vsebalkanske zveze združenj za odkrivanje naravnih proizvodov in zdravil (PANDA) in mednarodni seminarju Unescove regionalne mreže kemije naravnih proizvodov za varnost in dobro počutje v vseazijski in pacifiški regiji predstavljali naš nov izdelek GOBA Hericium erinaceus K in naše raziskovalne dosežke.

Naše podjetje se je pridružilo projektu IPANEMA, katerega glavno področje raziskav je razvoj biosenzorjev. https://www.ipanema2020.com/

Z veseljem sporočamo da smo preko Slovenskega podjetniškega sklada pridobili novo atmosfersko sušilno komoro v kateri bomo glive lahko sušili veliko hitreje, učinkoviteje in ob manjši porabi energije.

Nova študija na naših GOBA Trametes versicolor heteropolisaharidih, ki dokazuje da delujejo proti metabolnem sindromu, uravnava krvni pritisk in deluje protidiabetično. https://www.ncbi.nlm.nih.gov/pmc/articles/PMC10301780/
V sodelovanju z Univerzo v Nottingham-u in Univerzo Warwick, smo izvedli raziskavo o degeneraciji glivne kulture Cordyceps militaris in s tem povezano sintezo kordicepina / pentostatina.

Projekt eRECYn - Trajnostna pridelava standardiziranih prehranskih dopolnil iz glive Hericium (01.11.2022 - 30.11.2024) Cilj projekta je razviti prehransko dopolnilo iz zdravilne glive Hericium erinaceus v inovativni formulaciji, ki bo kot prva na svetu imela standardizirano in deklarirano vsebnost glavnega nevroprotektivnega sredstva erinacina A.

V okviru projekta je bilo razvito novo naravno prehransko dopolnilo iz medicinskih gliv vrste Cordyceps, ki je prvo prehransko dopolnilo z visoko in standardizirano vsebnostjo farmakološko aktivne snovi – kordicepina. Najnovejše znanstvene raziskave so potrdile pozitivne učinke kordicepina pri zdravljenju in preprečevanju številnih bolezni ter njegovo blagodejno delovanje na splošno počutje.
Se zanimate za prodajo izdelkov blagovne znamke GOBA®, ker bi jih želeli ponuditi v vaši fizični ali spletni trgovini?
 Prodaja surovin
Prodaja surovin
Za razvoj lastne blagovne znamke lahko pri nas naročite surovine iz medicinskih gob in mešanice, ki jih že proizvajamo, ali pa določeno vrsto gob vzgojimo prav za vas.